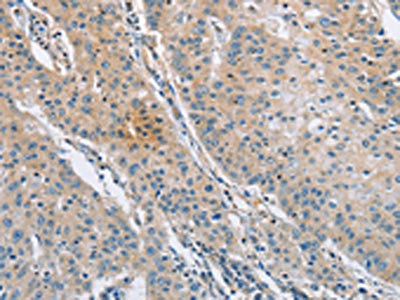

SH3GLB1 Antibody
-
中文名稱:SH3GLB1兔多克隆抗體
-
貨號:CSB-PA037961
-
規格:¥1100
-
圖片:
-
The image on the left is immunohistochemistry of paraffin-embedded Human gastic cancer tissue using CSB-PA037961(SH3GLB1 Antibody) at dilution 1/30, on the right is treated with fusion protein. (Original magnification: ×200)
-
The image on the left is immunohistochemistry of paraffin-embedded Human thyroid cancer tissue using CSB-PA037961(SH3GLB1 Antibody) at dilution 1/30, on the right is treated with fusion protein. (Original magnification: ×200)
-
-
其他:
產品詳情
-
Uniprot No.:
-
基因名:
-
別名:Bax interacting factor 1 antibody; Bax-interacting factor 1 antibody; Bif 1 antibody; Bif antibody; Bif-1 antibody; CGI 61 antibody; dJ612B15.2 antibody; Endophilin B1 antibody; Endophilin-B1 antibody; PPP1R70 antibody; Protein phosphatase 1 regulatory subunit 70 antibody; SH3 containing protein SH3GLB1 antibody; SH3 domain GRB2 like endophilin B1 antibody; SH3 domain-containing GRB2-like protein B1 antibody; Sh3glb1 antibody; SH3p13 antibody; SHLB1_HUMAN antibody
-
宿主:Rabbit
-
反應種屬:Human,Mouse,Rat
-
免疫原:Fusion protein of Human SH3GLB1
-
免疫原種屬:Homo sapiens (Human)
-
標記方式:Non-conjugated
-
抗體亞型:IgG
-
純化方式:Antigen affinity purification
-
濃度:It differs from different batches. Please contact us to confirm it.
-
保存緩沖液:-20°C, pH7.4 PBS, 0.05% NaN3, 40% Glycerol
-
產品提供形式:Liquid
-
應用范圍:ELISA,IHC
-
推薦稀釋比:
Application Recommended Dilution ELISA 1:1000-1:2000 IHC 1:15-1:50 -
Protocols:
-
儲存條件:Upon receipt, store at -20°C or -80°C. Avoid repeated freeze.
-
貨期:Basically, we can dispatch the products out in 1-3 working days after receiving your orders. Delivery time maybe differs from different purchasing way or location, please kindly consult your local distributors for specific delivery time.
-
用途:For Research Use Only. Not for use in diagnostic or therapeutic procedures.
相關產品
靶點詳情
-
功能:May be required for normal outer mitochondrial membrane dynamics. Required for coatomer-mediated retrograde transport in certain cells. May recruit other proteins to membranes with high curvature. May promote membrane fusion. Involved in activation of caspase-dependent apoptosis by promoting BAX/BAK1 activation. Isoform 1 acts proapoptotic in fibroblasts. Involved in caspase-independent apoptosis during nutrition starvation and involved in the regulation of autophagy. Activates lipid kinase activity of PIK3C3 during autophagy probably by associating with the PI3K complex II (PI3KC3-C2). Associated with PI3KC3-C2 during autophagy may regulate the trafficking of ATG9A from the Golgi complex to the peripheral cytoplasm for the formation of autophagosomes by inducing Golgi membrane tubulation and fragmentation. Involved in regulation of degradative endocytic trafficking and cytokinesis, probably in the context of PI3KC3-C2. Isoform 2 acts antiapoptotic in neuronal cells; involved in maintenance of mitochondrial morphology and promotes neuronal viability.
-
基因功能參考文獻:
- Here the authors report that Endophilin B2, similarly to Endophilin B1, plays an indispensable role in mitochondria sequestration and inner mitochondrial membrane (IMM) protein degradation during mitophagy. PMID: 27112121
- endophilin B1 participates in dynamin 2-dependent formation of a population of transport vesicles distinct from those generated by A-type endophilins PMID: 27508440
- Bif-1 is involved in prostate cancer tumorigenesis and acts as a suppressor in prostate cancer progression. PMID: 27748942
- endophilin B1 mediated the biological function of EGFR in cancer cell proliferation through regulating the EGFR endocytic trafficking and downstream signaling. PMID: 27609472
- these data reveal an Irgm1-dependent mechanism that promotes the tumorigenesis of melanoma via dual regulation of apoptosis and Bif-1-dependent autophagy PMID: 25619828
- Our findings suggest that endophilin-B1 is a key mediator of a feed-forward mechanism of Alzheimer's disease pathogenesis PMID: 25981964
- Data suggest that activated autophagy is associated with the progression of pancreatic ductal adenocarcinoma and that the overexpression of autophagy-related proteins Atg5, Ambra1, beclin-1, LC3B and Bif-1 is significantly correlated with poor outcome. PMID: 23429496
- these data suggest a novel function for Bif-1 as a suppressor of breast cancer cell migration by promoting EGFR degradation through the regulation of endosome maturation PMID: 22785202
- The expression of Bif-1 is downregulated in a subset of pancreatic ductal adenocarcinoma. This novel finding is in agreement with the tumor suppressor function of Bif-1. PMID: 21283040
- These findings suggest that Bif-1 acts as a critical regulator of Atg9 puncta formation presumably by mediating Golgi fission for autophagosome biogenesis during starvation. PMID: 21068542
- GSK-3beta promotes cell survival by modulating Bif-1-dependent autophagic response and cell death. PMID: 20159967
- Double knockdown of endophilin B1 and Drp1 leads to a mitochondrial phenotype identical to that of the Drp1 single knockdown, a result consistent with Drp1 acting upstream of endophilin B1 in the maintenance of morphological dynamics of mitochondria. PMID: 15452144
- Bif-1 is an important component of the mitochondrial pathway for apoptosis as a novel Bax/Bak activator, and loss of this proapoptotic molecule may contribute to tumorigenesis. PMID: 16227588
- BAR domain of endophilin-A1 drives membrane curvature by coordinate action of the crescent's scaffold mechanism and the ridge's membrane insertion in addition to membrane binding via amino-terminal amphipathic helix. PMID: 16763557
- The decreased expression of Bif-1 in malignant gastric epithelial cells compared with the normal mucosal cells suggests that loss of Bif-1 expression may play a role in gastric tumorigenesis, possibly by inhibiting the apoptosis mediated by Bif-1. PMID: 16916719
- Src phosphorylation of Bif-1 suppresses the interaction between Bif-1 and Bax, resulting in the inhibition of Bax activation during anoikis. PMID: 18474606
- Bif-1 expression might play a role in tumorigenesis in both urinary bladder (UB) and gallbladder (GB) cancer PMID: 18752120
- The loss of Bif-1 expression in a subset of prostate cancer samples is in agreement with the proapoptotic function of Bif-1. PMID: 18824435
- down-regulation of Bif-1 during the transition from normal colorectal mucosa to colorectal adenocarcinoma PMID: 18833585
- upregulation of Bif-1 could in part be responsible for tumorigenesis in cutaneous Merkel cell carcinoma PMID: 19125733
- Deregulation of Bif-1-related cell death is dependent not on Bif-1 mutation but on other mechanisms. PMID: 19132989
- Bax activates endophilin B1 oligomerization and lipid membrane vesiculation PMID: 19805544
顯示更多
收起更多
-
亞細胞定位:Cytoplasm. Golgi apparatus membrane; Peripheral membrane protein. Mitochondrion outer membrane; Peripheral membrane protein. Cytoplasmic vesicle, autophagosome membrane. Midbody.
-
蛋白家族:Endophilin family
-
組織特異性:Highly expressed in heart, skeletal muscle, kidney and placenta. Detected at lower levels in brain, colon, thymus, spleen, liver, small intestine, lung and peripheral blood leukocytes.
-
數據庫鏈接:
Most popular with customers
-
-
YWHAB Recombinant Monoclonal Antibody
Applications: ELISA, WB, IHC, IF, FC
Species Reactivity: Human, Mouse, Rat
-
-
-
-
-
-